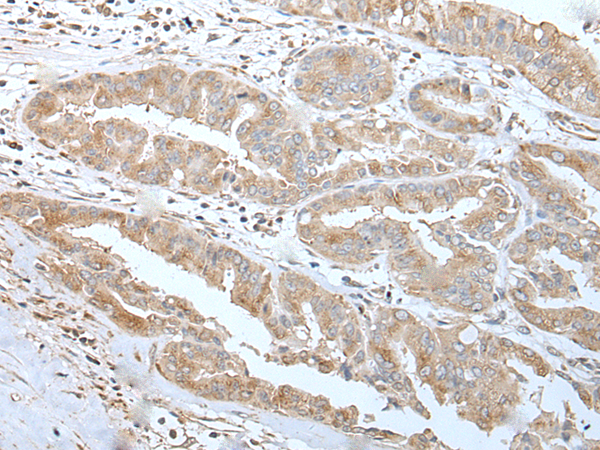
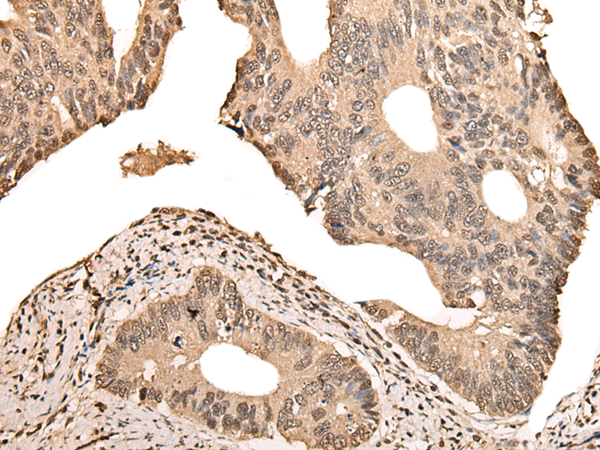
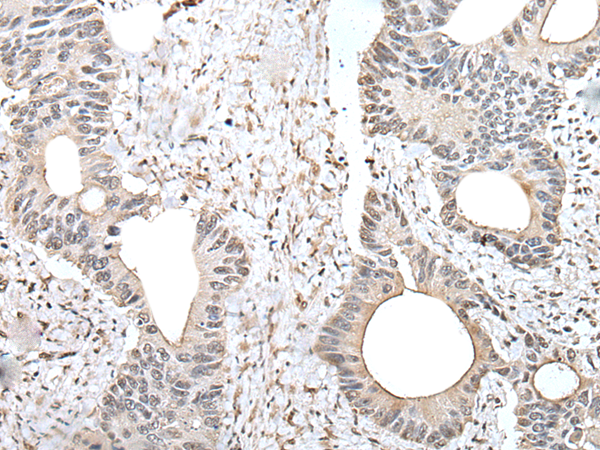
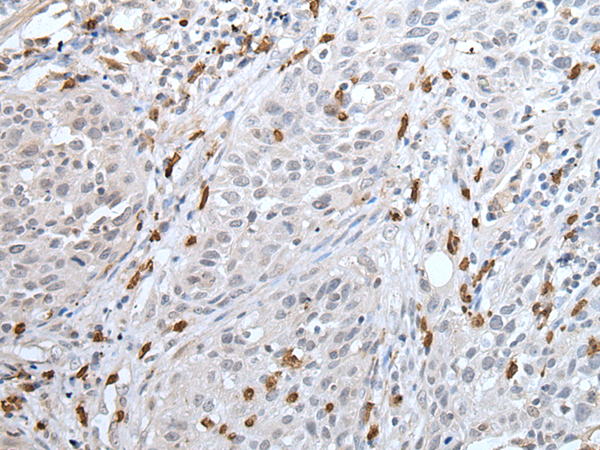
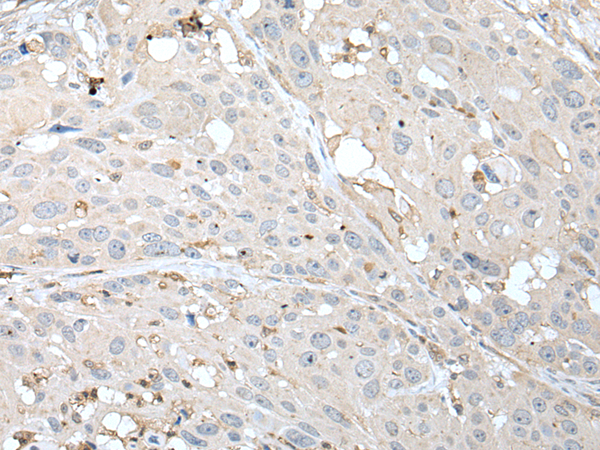

-
分类: 科研抗体货号: P09284别名: TAP; VDP; P115应用: WB,IHC反应种属: Human, Mouse
-
分类: 科研抗体货号: P09251别名: ZFP96; ZNF96; ZNF305; ZNF29K1; dJ29K1.2应用: IHC反应种属: Human
-
分类: 科研抗体货号: P09283别名: PORIN; VDAC-1应用: WB,IHC反应种属: Human, Mouse, Rat
-
分类: 科研抗体货号: P09266别名: XP1; XPAC应用: WB反应种属: Human, Mouse
-
分类: 科研抗体货号: P09250别名: HPF1; ZNF816B应用: IHC反应种属: Human
-
分类: 科研抗体货号: P09265别名: FKSG4应用: IHC反应种属: Human, Mouse
-
分类: 科研抗体货号: P09282别名: p97; TERA; ALS14; IBMPFD; HEL-220; IBMPFD1; HEL-S-70应用: WB,IHC反应种属: Human, Mouse, Rat
-
分类: 科研抗体货号: P09249别名: HF.18; Zfp128应用: WB,IHC反应种属: Human
-
分类: 科研抗体货号: P09264别名:应用: IHC反应种属: Human, Mouse
-
分类: 科研抗体货号: P09281别名:应用: WB,IHC反应种属: Human, Mouse

鄂公网安备42018502007531号
鄂公网安备42018502007531号

